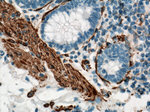
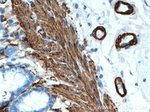

Search
Proteintech
ACTA2/smooth muscle actin Polyclonal Antibody
{{$productOrderCtrl.translations['antibody.pdp.commerceCard.promotion.promotions']}}
{{$productOrderCtrl.translations['antibody.pdp.commerceCard.promotion.viewpromo']}}
{{$productOrderCtrl.translations['antibody.pdp.commerceCard.promotion.promocode']}}: {{promo.promoCode}} {{promo.promoTitle}} {{promo.promoDescription}}. {{$productOrderCtrl.translations['antibody.pdp.commerceCard.promotion.learnmore']}}
产品信息
14395-1-AP
种属反应
已发表种属
宿主/亚型
分类
类型
抗原
偶联物
形式
浓度
规格
纯化类型
保存液
内含物
保存条件
运输条件
产品详细信息
This antibody may cross-react with other isoforms of actins.
Immunogen sequence: MCEEEDSTA LVCDNGSGLC KAGFAGDDAP RAVFPSIVGR PRHQGVMVGM GQKDSYVGDE AQSKRGILTL KYPIEHGIIT NWDDMEKIWH HSFYNELRVA PEEHPTLLTE APLNPKANRE KMTQIMFETF NVPAMYVAIQ AVLSLYASGR TTGIVLDSGD GVTHNVPIYE GYALPHAIMR LDLAGRDLTD YLMKILTERG YSFVTTAERE IVRDIKEKLC YVALDFENEM ATAASSSSLE KSYELPDGQV ITIGNERFRC PETLFQPSFI GMESAGIHET TYNSIMKCDI DIRKDLYANN VLSGGTTMYP GIADRMQKEI TALAPSTMKI KIIAPPERKY SVWIGGSILA SLSTFQQMWI SKQEYDEAGP SIVHRKCF (1-377 aa encoded by BC017554)
靶标信息
Smooth Muscle Actin belongs to the actin family of proteins, which are highly conserved proteins that play a role in cell motility, structure and integrity. Alpha, beta and gamma actin isoforms have been identified, with alpha actin being a major constituent of the contractile apparatus, while beta and gamma actins are involved in the regulation of cell motility. In particular, smooth muscle actin is an alpha actin that is found in skeletal muscle. Actin exists as a ubiquitous protein involved with filament formation that make up large portions of the cytoskeleton. Actin filaments interact with myosin to assist in muscle contraction as well as aiding in cell motility and cytokinesis. Smooth muscle actin is found on smooth muscle vessel walls, gut wall, myometrium, myoepithelial cells in breast and salivary glands. Defects in the smooth muscle actin gene cause aortic aneurysm familial thoracic type 6. Actin isoforms differ slightly in their N-terminus and the sequences of each are perfectly conserved in higher vertebrates. Alpha-smooth muscle actin is abundant in vascular and visceral smooth muscle cells. In addition, it has also been shown that smooth muscle actin appear in stress fibers of fibroblastic cells during pathological situations involving contractile phenomena such as wound healing and fibrocontractive diseases. Multiple alternatively spliced variants of smooth muscle actin have been identified.
仅用于科研。不用于诊断过程。未经明确授权不得转售。
生物信息学
蛋白别名: ACTA2; Actin Alpha 2 Smooth Muscle Aorta; Actin Vascular Smooth Muscle; actin, alpha 2, smooth muscle, aorta; actin, alpha, vascular smooth muscle; Actin, aortic smooth muscle; Alpha Cardiac Actin; alpha-actin; Alpha-actin-2; alpha-cardiac actin; Aortic Smooth Muscle; asma; Cell growth-inhibiting gene 46 protein; GIG46; Growth Inhibiting Gene 46; smooth muscle; smooth muscle alpha-actin; unnamed protein product
基因别名: 0610041G09Rik; a-SMA; ACTA2; ACTSA; ACTVS; alphaSMA; GIG46; SMalphaA; SMDYS
UniProt ID: (Human) P62736, (Rat) P62738, (Mouse) P62737
Entrez Gene ID: (Human) 59, (Rat) 81633, (Mouse) 11475